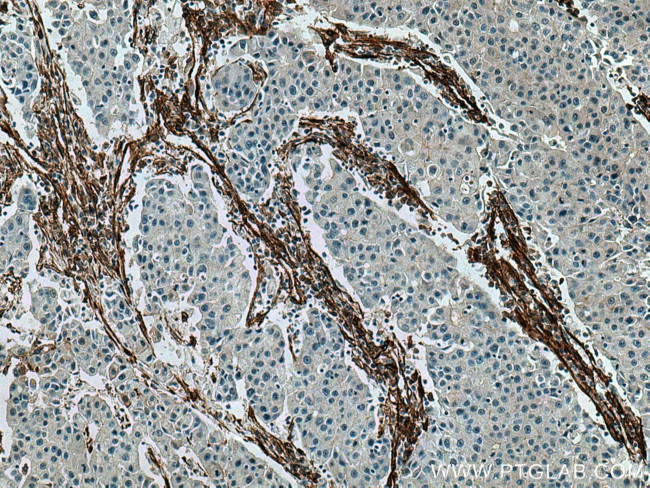
Caveolin-1 Antibody in Immunohistochemistry (Paraffin) (IHC (P))

Search
Proteintech
Caveolin-1 Monoclonal Antibody (6C2B2)
{{$productOrderCtrl.translations['antibody.pdp.commerceCard.promotion.promotions']}}
{{$productOrderCtrl.translations['antibody.pdp.commerceCard.promotion.viewpromo']}}
{{$productOrderCtrl.translations['antibody.pdp.commerceCard.promotion.promocode']}}: {{promo.promoCode}} {{promo.promoTitle}} {{promo.promoDescription}}. {{$productOrderCtrl.translations['antibody.pdp.commerceCard.promotion.learnmore']}}
产品信息
66067-1-IG
种属反应
已发表种属
宿主/亚型
分类
类型
克隆号
抗原
偶联物
形式
浓度
规格
纯化类型
保存液
内含物
保存条件
运输条件
产品详细信息
Immunogen sequence: GHLYTVPIR EQGNIYKPNN KAMADELSEK QVYDAHTKEI DLVNRDPKHL NDDVVKIDFE DVIAEPEGTH SFDGIWKASF TTFTVTKYWF YRLLSALFGI PMALIWGIYF AILSFLHIWA VVPCIKSFLI EIQCISRVYS IYVHTVCDPL FEAVGKIFSN VRINLQKEI (11-179 aa encoded by BC006432)
靶标信息
Caveolin-1 or CAV1 is a scaffolding proteins within caveolar membranes. It interacts directly with G-protein alpha subunits and can functionally regulate their activity. Caveolin-1 is also involved in the co-stimulatory signal essential for T-cell receptor (TCR) mediated T-cell activation. It can bind with DPP4 and induces T-cell proliferation and NF-kappa-B activation in a T-cell receptor/CD3-dependent manner. Mutations affecting the CAV1 gene can result in congenital generalized lipodystrophy 3, pulmonary hypertension primary 3, or partial lipodystrophy/congenital cataracts, and neurodegeneration syndrome.
仅用于科研。不用于诊断过程。未经明确授权不得转售。
生物信息学
蛋白别名: CAV1; caveolae; caveolin 1, caveolae protein, 22kDa; caveolin caveolae protein 22 kDa; caveolin, caveolae protein 1; caveolin, caveolae protein, 22 kDa; Caveolin-1; cell growth-inhibiting protein 32; GIG32; HGNC:1527; OTTHUMP00000196475; unnamed protein product
基因别名: BSCL3; CAV; Cav-1; CAV1; CGL3; LCCNS; MSTP085; PPH3; VIP21
UniProt ID: (Pig) Q6RVA9, (Human) Q03135, (Mouse) P49817
Entrez Gene ID: (Pig) 404693, (Human) 857, (Mouse) 12389, (Rat) 25404